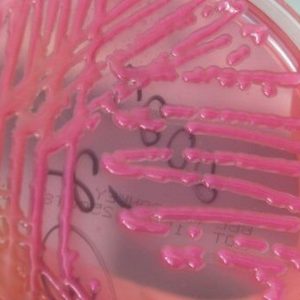

Klebsiella tünetek és Klebsiella pneumonia, Klebsiella egy kenetet, mint a gyógyítás klebsiellu

Klebsiella - opportunista patogén, amely okozhat a különböző fertőző betegségek, beleértve a súlyos szeptikus megnyilvánulásai. A betegség súlyossága attól függ, hogy a feltétele az immunrendszer az egyén.
Klebsiella - mi ez
Klebsiella - egy Gram-negatív pálcák a biológiai szinten (azaz, Gram-festéssel nem lila), a méret a mikroorganizmus 1x6 mm. Klebsiella alakú pálca, ezek teljesen mozdulatlan, lehet elhelyezni párokat vagy egyedül, gyakran rendezett egy láncban.
Normál fiziológiás körülmények között, Klebsiella nem valami szokatlan, hiszen a szervezet része a bélflóra és az egész emésztőrendszert. Továbbá, ez a opportunista patogén lehet jelen a nyálkahártya a légúti és a bőrön. Életfunkciók Klebsiella tárolódik a talajban és a vízben, a por és az élelmiszerekben tárolható a hűtőszekrényben.
Okai fertőzés
A fertőzés forrása - az a személy már fertőzött klebsielleznoy fertőzés. A belek kibír ott a következő esetekben:
- higiénia hiánya szabályok;
- eszik rendetlen gyümölcsök és zöldségek;
- Folyamatosan piszkos kézzel.
Tényezői átviteli gyakran szolgálnak élelmiszerek - mint például a gyümölcsök, tejtermékek, zöldségek és húskészítmények.
Ha a beteg a tüdőgyulladás. a többiek által fertőzött levegőben lebegő cseppek. Úgy gondolják, hogy, hogy fogékonyak általános jellegű, de az orvosok megkülönböztetni bizonyos kockázata, amely magában foglalja:
- betegek gyógyulási időszak után a transzplantációs szervek és / vagy szövetek;
- diagnosztizált betegek onkológiai betegségek, patológiák a vér és / vagy a cukorbetegség;
- szenvedők alkoholizmus;
- idősek meglévő immunhiányos állapot;
- gyermekek és újszülöttek.
Ha Klebsiella van az emberi bélben, az általa előállított endotoxin, ami a pusztulását a mikroorganizmus vizsgálják. Ez a mechanizmus az oka a fertőző-toxikus reakció típusú.
Továbbá endotoxin Klebsiella előállítására alkalmas hőálló enterotoxin és membranotoksin. Eredeti toxin vezet bélnyálkahártya elváltozás, amely megnyilvánul a folyékony vizes széklet. A membranotoksin magas hemolitikus aktivitás - ez közvetlenül befolyásolja a bél sejtjei.
Klebsiella fertőzés: fertőzést
A fertőzés után került az emberi szervezetben elkezdődik az inkubációs periódus időtartama lehet egy időszak néhány óra és néhány nap alatt. Miután az inkubációs időszak végén, Klebsiella nyilvánvaló súlyos tünetek, ami függ a lokalizáció a mikroorganizmus.
Ha Klebsiella fény csapott, fejlődik klebsielleznaya tüdőgyulladás. Ez nyilvánvaló a következő tünetek:
- hidegrázás, túlzott izzadás, gyengeség és erős;
- testhőmérséklet emelkedése, esetleg akár 39 fok;
- száraz köhögés jellege. rövid idő után is van, gennyes köpet kevert vér (a köpet jellemző egy nagyon kellemetlen szaga);
- légszomj. elég erős;
- hallgatása közben a tüdő határozza meg a légzés csillapítás gyulladás;
- Míg kopogás által meghatározott nedves vagy száraz zörejek, tompaság;
- Röntgensugarak tendenciát mutat, hogy egyesíti beszivárgás gócok.
Megjegyzés: ha a kezelés klebsielleznoy fertőzést végzünk gyors és korrekt, a behajtás esélye van maximum. Ha a kezelés nem áll rendelkezésre, akkor a fertőzés terjedését és fejleszteni vérmérgezés - egy életveszélyes állapot a személy.
Ha Klebsiella befolyásolja a felső légúti traktus és a nyálkahártyát az orr, a következő tünetek vannak jelen:
- Oktatási rinoskleromy. A granulomák vannak kialakítva a héj a felső légutakban, és az orr, ezek lokalizáltak mikroorganizmusok provokál bőséges nazális nyálkás-gennyes jellegéről, és jellegzetes illatot, orrdugulás.
- A krónikus betegségek, a légcső és a nasopharynx. Jellemzőjük a gennyes váladék a nazális szekréciót átható szag, képződése kéreg felületén a nyálkahártya, torokfájás és köhögés erős köptetést.
Tünetei léziók tekinthető opportunista patogének a gyomor-bél traktus:
- hasi fájdalom. hányinger. gyomorégés. jelentős étvágy csökkenése;
- az akut enterocolitis, ha ütött a belek;
- láz;
- hasmenés;
- a vér jelenlétét a székletben. nyák;
- bűzös szag ürülék.
Ha Klebsiella „rendezni” a vizeletben, meg fog jelenni a következő tünetek:
- ingerlékenység, ami a beteg nem tud uralkodni magán;
- fejlesztése pyelonephritis;
- fejlesztése hólyaggyulladás
- vannak jelei a gyulladás a prosztata.
diagnosztikai eszközök

Kutatási módszerek diagnózis:
- beoltás anyag tápközegben;
- bacterioscopy (Gram-festés);
- szerológiai módszerekkel;
- coprogram.
Szabályok kezelésére Klebsiella
Terápiás stratégia attól függ, hogy a betegség manifesztálódik konkrétan mennyit húzza folyamatot. Ha Klebsiella meglepte a belek, de a fertőzés enyhe, akkor a kezelést elvégezni ambuláns és használatával bakteriofágok és probiotikumok.
Szabályzat kezelésére Klebsiella bakteriofágok:
- olyan gyógyszerek adagolásával hajtjuk végre 3-szor naponta, étkezés előtt;
- gyermekek nulláról hat hónapon egyetlen adag 5 ml;
- a gyermekek 6 és 12 hónap egyszeri adag - 10 ml;
- éves gyermekek 1-3 éves egyszeri adag - 15 ml;
- éves gyermekek 3-7 év, egy egyszeri adag - 20 ml;
- gyermekeknek 8 éves, és minden felnőtt egyszeri adag - 30 ml.
A fertőzések kezelésére tekinthető probiotikumok használnak, például Bifiform, Lineks, Probifor, Atsipol, Bifilong, Biovestin, Bifidumbacterin és mások. A kurzus az ilyen gyógyszerek tartson legalább 10 nap, és az optimális kúrát 14-21 nap.
Megjegyezzük, hogy a dózis probiotikumok választjuk szigorúan egyéni alapon!

Klebsiella kezelést kiegészíthetjük patogenetikai terápia, amely csökkenteni fogja a lázas szindrómák, mérgezés, és úgy járnak, mint profilaktikus szer kapcsolatos szövődmények kifejlődését.
lehetséges szövődmények
Ha a fertőzés súlyos és diagnosztizálni a tüdőgyulladás vagy szepszis, a következő szövődmények alakulhatnak ki:
Miután átesett Klebsiella jelentősen gyengíti az immunrendszert, így lehet könnyen megtörténhet visszaesés.
Megtekintett opportunista patogének ravasz elég, és meg kell, hogy tegyen meg minden erőfeszítést, hogy ne alakuljon ki fertőzés. És ez elég ahhoz, hogy tartsa be a személyi higiéniára, evés csak frissen mosott gyümölcs és zöldség.